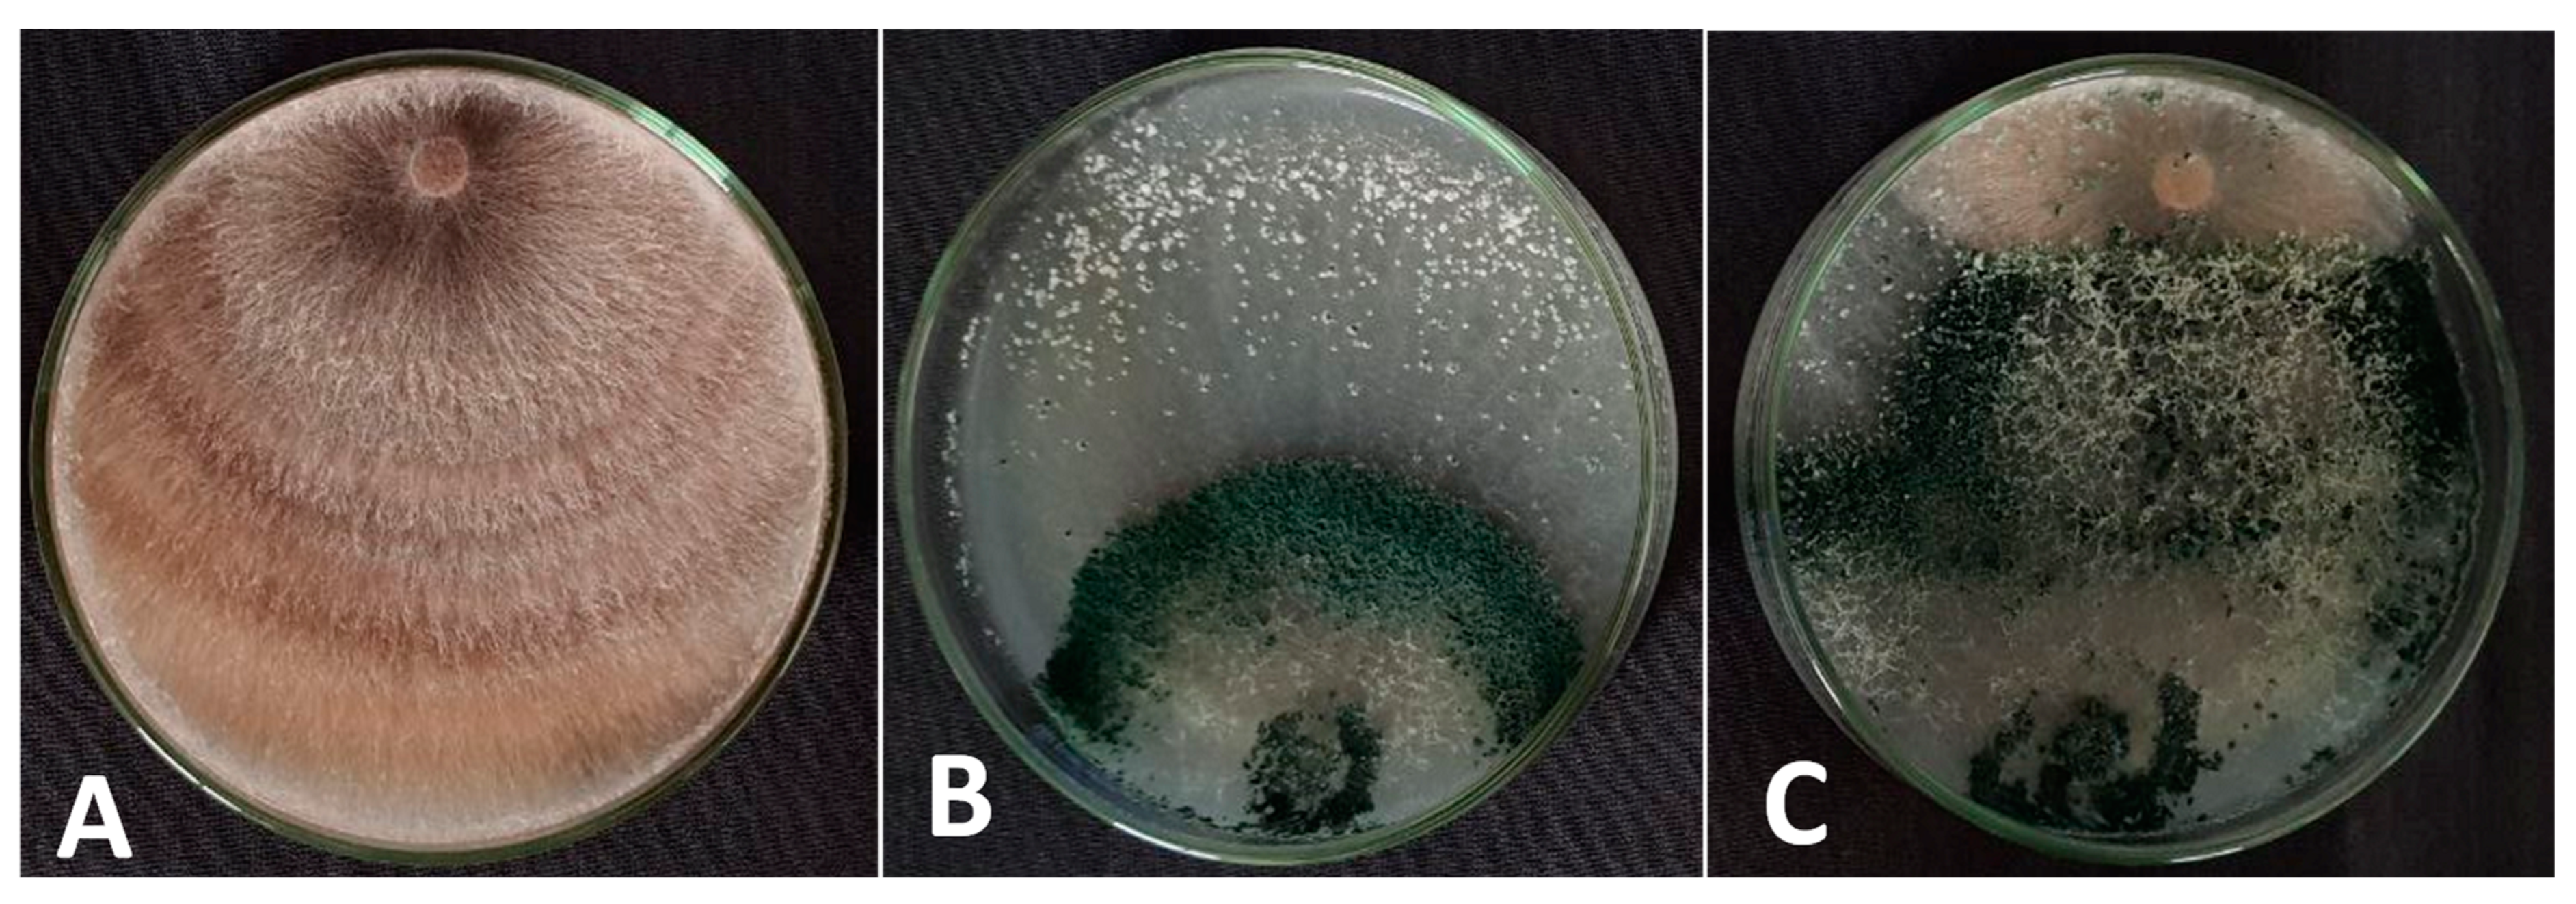

A Simple Formula of the Endophytic Trichoderma viride, a Case Study for the Management of Rhizoctonia solani on the Common Bean
Abstract
1. Introduction
2. Materials and Methods
2.1. The Pathogenic and Endophytic Fungi
2.2. Molecular Identification
2.3. T. viride vis R. solani
2.4. Culturing Conditions
2.5. Analysis of Gas Chromatography–Mass Spectrometry (GC-MS)
2.6. Granular Formulation of T. viride into Marketable Product
2.6.1. Evaluation of the Marketable Product
2.6.2. Shelf-Life Viability of GBTF
2.7. In Vivo Experiments
2.7.1. The Pathogen, and Inoculum Preparation
2.7.2. Greenhouse Experimental Design
2.7.3. Disease Assessment
2.7.4. Physiological Activities of Bean Plants
2.7.5. Analysis of Growth and Yield Parameters
2.8. Statistical Procedure
3. Results
3.1. Molecular Identification
3.2. T. viride Filtrate Analysis Using GC-MS
3.3. Dual Culture Test
3.4. Shelf-Life Viability of the Marketable Formula
3.5. In Vivo Study
3.5.1. GBTF Evaluation of the Development of Root Rot
3.5.2. Growth and Yield
3.5.3. Physiological Activities of Common Bean Plant
4. Discussion
5. Conclusions
Supplementary Materials
Author Contributions
Funding
Institutional Review Board Statement
Informed Consent Statement
Data Availability Statement
Conflicts of Interest
References
- He, D.C.; He, M.H.; Amalin, D.M.; Liu, W.; Alvindia, D.G.; Zhan, J. Biological control of plant diseases: An evolutionary and eco-Economic consideration. Pathogens 2021, 10, 1311. [Google Scholar] [CrossRef] [PubMed]
- Tyśkiewicz, R.; Nowak, A.; Ozimek, E.; Jaroszuk-Sciseł, J. Trichoderma: The current status of its application in agriculture for the biocontrol of fungal phytopathogens and stimulation of plant growth. Int. J. Mol. Sci. 2022, 23, 2329. [Google Scholar] [CrossRef] [PubMed]
- Liu, Y.; He, P.; He, P.; Munir, S.; Ahmed, A.; Wu, Y.; Yang, Y.; Lu, J.; Wang, J.; Yang, J.; et al. Potential biocontrol efficiency of Trichoderma species against oomycete pathogens. Front. Microbiol. 2022, 13, 974024. [Google Scholar] [CrossRef]
- Guzmán-Guzmán, P.; Kumar, A.; de los Santos-Villalobos, S.; Parra-Cota, F.I.; Orozco-Mosqueda, M.d.C.; Fadiji, A.E.; Hyder, S.; Babalola, O.O.; Santoyo, G. Trichoderma species: Our best fungal allies in the biocontrol of plant diseases—A review. Plants 2023, 12, 432. [Google Scholar] [CrossRef]
- Solanki, M.K.; Singh, N.; Singh, R.K.; Singh, P.; Srivastava, A.K.; Kumar, S.; Kashyap, P.L.; Arora, D.K. Plant defense activation and management of tomato root rot by a chitin-fortified Trichoderma/Hypocrea formulation. Phytoparasitica 2011, 39, 471–481. [Google Scholar] [CrossRef]
- Kashyap, P.L.; Solanki, M.K.; Kushwaha, P.; Kumar, S.; Srivastava, A.K. Biocontrol potential of salt-tolerant Trichoderma and Hypocrea isolates for the management of tomato root rot under saline environment. J. Soil Sci. Plant Nutr. 2020, 20, 160–176. [Google Scholar] [CrossRef]
- Abbas, A.; Mubeen, M.; Zheng, H.; Sohail, M.A.; Shakeel, Q.; Solanki, M.K.; Iftikhar, Y.; Sharma, S.; Kashyap, B.K.; Hussain, S.; et al. Trichoderma spp. genes involved in the biocontrol activity against Rhizoctonia solani. Front. Microbiol. 2022, 13, 884469. [Google Scholar] [CrossRef]
- Alfiky, A.; Weisskopf, L. Deciphering Trichoderma–Plant–Pathogen Interactions for Better Development of Biocontrol Applications. J. Fungi 2021, 7, 61. [Google Scholar] [CrossRef]
- Kalavacharla, V.; Liu, Z.; Meyers, B.C.; Thimmapuram, J.; Melmaiee, K. Identification and analysis of common bean (Phaseolus vulgaris L.) transcriptomes by massively parallel pyrosequencing. BMC Plant Biol. 2011, 11, 118–135. [Google Scholar] [CrossRef]
- Rodríguez Madrera, R.; Campa Negrillo, A.; Suárez Valles, B.; Ferreira Fernández, J.J. Phenolic content and antioxidant activity in seeds of common bean (Phaseolus vulgaris L.). Foods 2021, 10, 864. [Google Scholar] [CrossRef]
- Costa, G.E.A.; da Silva Queiroz-Monici, K.; Reis, S.M.P.M.; de Oliveira, A.C. Chemical composition, dietary fibre and resistant starch contents of raw and cooked pea, common bean, chickpea and lentil legumes. Food Chem. 2006, 94, 327–330. [Google Scholar] [CrossRef]
- Howieson, J.G.; Yates, R.J.; Foster, K.J.; Real, D.; Besier, R.B. Prospects for the future use of legumes. In Nitrogen-Fixing Leguminous Symbioses; Springer: Dordrecht, The Netherlands, 2008; pp. 363–394. [Google Scholar] [CrossRef]
- Torres, S.V.; Vargas, M.M.; Godoy-Lutz, G.; Porch, T.G.; Beaver, J.S. Isolates of Rhizoctonia solani can produce both web blight and root rot symptoms in common bean (Phaseolus vulgaris L.). Plant Dis. 2016, 100, 1351–1357. [Google Scholar] [CrossRef] [PubMed]
- Nerey, Y.; Pannecoucque, J.; Hernandez, H.P.; Diaz, M.; Espinosa, R.; De Vos, S.; Van Beneden, S.; Herrera, L.; Höfte, M. Rhizoctonia spp. causing root and hypocotyl rot in Phaseolus vulgaris in Cuba. J. Phytopathol. 2010, 158, 236–243. [Google Scholar] [CrossRef]
- Singh, S.P.; Schwartz, H.F. Breeding common bean for resistance to diseases: A review. Crop. Sci. 2010, 50, 2199–2223. [Google Scholar] [CrossRef]
- Yang, G.; Li, C. General description of Rhizoctonia species complex. In Plant Pathology; Cumagun, C.J., Ed.; IntechOpen: Rijeka, Croatia, 2012; pp. 41–52. [Google Scholar] [CrossRef]
- Mayo, S.; Gutiérrez, S.; Malmierca, M.G.; Lorenzana, A.; Campelo, M.P.; Hermosa, R.; Casquero, P.A. Influence of Rhizoctonia solani and Trichoderma spp. in growth of bean (Phaseolus vulgaris L.) and in the induction of plant defense-related genes. Front. Plant Sci. 2015, 6, 685. [Google Scholar] [CrossRef] [PubMed]
- Boyette, C.D.; Quimby Jr, P.C.; Caesar, A.J.; Birdsall, J.L.; Connick, W.J., Jr.; Daigle, D.J.; Jackson, M.A.; Egley, G.H.; Abbas, H.K. Adjuvants, formulations, and spraying systems for improvement of mycoherbicides. Weed Technol. 1996, 10, 637–644. [Google Scholar] [CrossRef]
- Connick, W.; Daigle, D.; Quimby, P. An improved invert emulsion with high water retention for mycoherbicide delivery. Weed Technol. 1991, 5, 442–444. [Google Scholar] [CrossRef]
- Bharti, V.S.; Dotaniya, M.L.; Shukla, S.P.; Yadav, V.K. Managing soil fertility through microbes: Prospects, challenges and future strategies. In Agro-Environmental Sustainability; Singh, J.S., Seneviratane, G., Eds.; Springer International Publishing AG: Berlin/Heidelberg, Germany, 2017; pp. 81–111. [Google Scholar] [CrossRef]
- Komala, G.; Madhavi, G.B.; Nath, R. Shelf life studies of different formulations of Trichoderma harzianum. Plant Cell Biotechnol. Mol. Biol. 2019, 20, 1100–1105. [Google Scholar]
- Herrera, W.; Valbuena, O.; Pavone-Maniscalco, D. Formulation of Trichoderma asperellum TV190 for biological control of Rhizoctonia solani on corn seedlings. Egypt. J. Biol. Pest Control 2020, 30, 44. [Google Scholar] [CrossRef]
- Saitou, N.; Nei, M. The neighbor-joining method: A new method for reconstructing phylogenetic trees. Mol. Biol. Evol. 1987, 4, 406–425. [Google Scholar] [CrossRef]
- Tamura, K.; Stecher, G.; Kumar, S. MEGA 11: Molecular Evolutionary Genetics Analysis Version 11. Molecular Biology and Evolution; Oxford Academic: Oxford, UK, 2021. [Google Scholar] [CrossRef]
- Dhingra, O.D.; Sinclari, J.B. Basic Plant Pathology Methods, 2nd ed.; CRC Press: Boca Raton, FL, USA, 1995; p. 434. [Google Scholar]
- Bell, D.K.; Wells, H.D.; Markham, C.R. In vitro antagonism of Trichoderma species against six fungal plant pathogens. Phytopathology 1982, 72, 379–382. [Google Scholar] [CrossRef]
- Greenspan, L. Humidity fixed points of binary saturated aqueous solutions. J. Res. Natl. Bur. Stand. A Phys. Chem. 1977, 81A, 89–96. [Google Scholar] [CrossRef]
- Connick, W.J., Jr.; Daigle, D.J.; Boyette, C.D.; Williams, K.S.; Vinyard, B.T.; Quimby, B.C., Jr. Water activity and other factors that affect the viability of Colletotrichum truncatum conidia in wheat flour-kaolin granules (‘Pesta’). Biocontrol Sci. Technol. 1996, 6, 277–284. [Google Scholar] [CrossRef]
- Carling, D.E.; Pope, E.J.; Brainard, K.A.; Carter, D.A. Characterization of mycorrhizal isolates of Rhizoctonia solani from an orchid, including AG-12, a new anastomosis group. Phytopathology 1999, 89, 942–946. [Google Scholar] [CrossRef]
- Malik, C.P.; Singh, M.B. Estimation of total phenols in plant enzymology and histoenzymology. In Plant Enzymology and Histo-enzymology: A Text Manual; Malik, C.P., Singh, M.B., Eds.; Kalyani Publishers: New Delhi, Kalyani, India, 1980; p. 282. [Google Scholar]
- Lusso, M.F.G.; Pascholati, S.F. Activity and isoenzymatic pattern of soluble peroxidases in maize tissues after mechanical injury or fungal inoculation. Summa Phytopathol. 1999, 25, 244–249. [Google Scholar]
- Galeazzi, M.A.M.; Sgarbieri, V.C.; Constantinides, S.M. Isolation, purification and physicochemical characterization of polyphenoloxidases (PPO) from a dwarf variety of banana (Musa cavendishii, L.). J. Food Sci. 1981, 46, 150–155. [Google Scholar] [CrossRef]
- Maxwell, D.P.; Bateman, D.F. Changes in the activities of some oxidases in extracts of Rhizoctonia-infected bean hypocotyl in relation to lesion maturation. Phytopathology 1967, 57, 132. [Google Scholar]
- Mackinney, G. Absorption of light by cholorophyll solution. J. Bio. Chem. 1941, 140, 315–322. [Google Scholar] [CrossRef]
- Al-Askar, A.A.; Saber, W.I.A.; Ghoneem, K.M.; Hafez, E.E.; Ibrahim, A.A. Crude citric acid of Trichoderma asperellum: Tomato growth promotor and suppressor of Fusarium oxysporum f. sp. lycopersici. Plants 2021, 10, 222. [Google Scholar] [CrossRef]
- Inglis, P.W.; Tigano, M.S. Identification and taxonomy of some entomopathogenic Paecilomyces spp. (Ascomycota) isolates using rDNA-ITS sequences. Genet. Mol. Biol. 2006, 29, 132–136. [Google Scholar] [CrossRef]
- Raja, H.A.; Miller, A.N.; Pearce, C.J.; Oberlies, N.H. Fungal identification using molecular tools: A primer for the natural products research community. J. Nat. Prod. 2017, 80, 756–770. [Google Scholar] [CrossRef]
- Al-Askar, A.A.; Rashad, E.M.; Ghoneem, K.M.; Mostafa, A.A.; Al-Otibi, F.O.; Saber, W.I.A. Discovering Penicillium polinicum with high-lytic capacity on Helianthus tuberosus tubers: Oil-based preservation for mold management. Plants 2021, 10, 413. [Google Scholar] [CrossRef] [PubMed]
- Yassin, M.T.; Mostafa, A.A.; Al-Askar, A.A.; Sayed, S.R.M.; Rady, A.M. Antagonistic activity of Trichoderma harzianum and Trichoderma viride strains against some fusarial pathogens causing stalk rot disease of maize, in vitro. J. King Saud Univ. Sci. 2021, 33, 101363. [Google Scholar] [CrossRef]
- Řiháková, Z.; Plocková, M.; Filip, V.; Šmidrkal, J. Antifungal activity of lauric acid derivatives against Aspergillus niger. Eur. Food Res. Technol. 2001, 213, 488–490. [Google Scholar] [CrossRef]
- Desbois, A.P.; Lebl, T.; Yan, L.; Smith, V.J. Isolation and structural characterisation of two antibacterial free fatty acids from the marine diatom, Phaeodactylum tricornutum. Appl. Microbiol. Biotechnol. 2008, 81, 755–764. [Google Scholar] [CrossRef]
- Lanzuise, S.; Manganiello, G.; Guastaferro, V.M.; Vincenzo, C.; Vitaglione, P.; Ferracane, R.; Vecchi, A.; Vinale, F.; Kamau, S.; Lorito, M.; et al. Combined biostimulant applications of Trichoderma spp. with fatty acid mixtures improve bio-control activity, Horticultural crop yield and nutritional quality. Agronomy 2022, 12, 275. [Google Scholar] [CrossRef]
- Mohy El-Din, S.M.; Mohyeldin, M.M. Component analysis and antifungal activity of the compounds extracted from four brown seaweeds with different solvents at different seasons. J. Ocean Univ. China 2018, 17, 1178–1188. [Google Scholar] [CrossRef]
- Cai, R.; Hu, M.; Zhang, Y.; Niu, C.; Yue, T.; Yuan, Y.; Wang, Z. Antifungal activity and mechanism of citral, limonene and eugenol against Zygosaccharomyces rouxii. LWT 2019, 106, 50–56. [Google Scholar] [CrossRef]
- Walters, D.R.; Walker, R.L.; Walker, K.C. Lauric acid exhibits antifungal activity against plant pathogenic fungi. J. Phytopathol. 2003, 151, 228–230. [Google Scholar] [CrossRef]
- Altieri, C.; Cardillo, D.; Bevilacqua, A.; Sinigallia, M. Inhibition of Aspergillus spp. and Penicillium spp. by fatty acids and their monoglycerides. J. Food Prot. 2007, 70, 1206–1212. [Google Scholar] [CrossRef]
- Saravanakumar, K.; Chelliah, R.; Ramakrishnan, S.R.; Kathiresan, K.; Oh, D.H.; Wang, M.H. Antibacterial, and antioxidant potentials of non-cytotoxic extract of Trichoderma atroviride. Microb. Pathog. 2018, 115, 338–342. [Google Scholar] [CrossRef] [PubMed]
- Javaid, A.; Latif, U.; Akhtar, N.; Ahmed, D.; Perveen, S. Molecular characterization of Fusarium moniliforme and its management by methanolic extract of Coronopus didymus. Pak. J. Bot. 2018, 50, 2069–2075. [Google Scholar]
- Javaid, A.; Shahzad, G.R.; Akhtar, N.; Ahmed, D. Alternaria leaf spot disease of broccoli in Pakistan and management of the pathogen by leaf extract of Syzygium cumini. Pak. J. Bot. 2018, 50, 1607–1614. [Google Scholar]
- Shaaban, M.T.; Ghaly, M.F.; Fahmi, S.M. Antibacterial activities of hexadecanoic acid methyl ester and green-synthesized silver nanoparticles against multidrug-resistant bacteria. J. Basic Microbiol. 2021, 61, 557–568. [Google Scholar] [CrossRef] [PubMed]
- Qiao, H.; Meifang, Z.; Shuyong, W. Progress on the antimicrobial activity research of clove oil and eugenol in the food antisepsis field. J. Food Sci. 2018, 83, 1476–1483. [Google Scholar] [CrossRef]
- Semwal, P.; Painuli, S.; Badoni, H.; Bacheti, R.K. Screening of phytoconstituents and antibacterial activity of leaves and bark of Quercus leucotrichophora A. Camus from Uttarakhand Himalaya. Clin. Phytosci. 2018, 4, 30. [Google Scholar] [CrossRef]
- Mulatu, A.; Megersa, N.; Tolcha, T.; Alemu, T.; Vetukuri, R.R. Antifungal compounds, GC-MS analysis and toxicity assessment of methanolic extracts of Trichoderma species in an animal model. PLoS ONE 2022, 17, e0274062. [Google Scholar] [CrossRef] [PubMed]
- Muthukrishnan, S.; Prakathi, P.; Sivakumar, T.; Thiruvengadam, M.; Jayaprakash, B.; Baskar, V.; Rebezov, M.; Derkho, M.; Zengin, G.; Shariati, M.A. Bioactive components and health potential of endophytic micro-fungal diversity in medicinal plants. Antibiotics 2022, 11, 1533. [Google Scholar] [CrossRef]
- Mohammed, G.J.; Kadhim, M.J.; Hussein, H.M. Characterization of bioactive chemical compounds from Aspergillus terreus and evaluation of antibacterial and antifungal activity. Int. J. Pharmacogn. Phytochem. Res. 2016, 8, 889–905. [Google Scholar]
- Singh, U.B.; Malviya, D.; Singh, S.; Pradhan, J.K.; Singh, B.P.; Roy, M.; Imran, M.; Pathak, N.; Baisyal, B.M.; Rai, J.; et al. Bio-protective microbial agents from rhizosphere eco-systems trigger plant defense responses provide protection against sheath blight disease in rice (Oryza sativa L.). Microbiol. Res. 2016, 192, 300–312. [Google Scholar] [CrossRef]
- Abbas, A.; Jiang, D.; Fu, Y. Trichoderma spp. as antagonist of Rhizoctonia solani. J. Plant Pathol. Microbiol. 2017, 8, 402. [Google Scholar] [CrossRef]
- Sood, M.; Kapoor, D.; Kumar, V.; Sheteiwy, M.S.; Ramakrishnan, M.; Landi, M.; Araniti, F.; Sharma, A. Trichoderma: The “secrets” of a multitalented biocontrol agent. Plants 2020, 9, 762. [Google Scholar] [CrossRef] [PubMed]
- Awad, N.E.; Kassem, H.A.; Hamed, M.A.; Elfiki, A.M.; Elnaggar, M.A.A.; Mahmoud, K.; Ali, M.A. Isolation and characterization of the bioactive metabolites from the soil derived fungus Trichoderma viride. Mycology 2018, 9, 70–80. [Google Scholar] [CrossRef]
- Kotasthane, A.; Agrawal, T.; Kushwah, R.; Rahatkar, O.V. In-vitro antagonism of Trichoderma spp. against Sclerotium rolfsii and Rhizoctonia solani and their response towards growth of cucumber, bottle gourd and bitter gourd. Eur. J. Plant Pathol. 2015, 141, 523–543. [Google Scholar] [CrossRef]
- Krishnamurthy, J.; Samiyappan, R.; Vidhyasekaran, P.; Nakkeeran, S.; Rajeswari, E. Efficacy of Trichoderma chitinases against Rhizoctonia solani, the rice sheath blight pathogen. J. Biosci. 1999, 24, 207–213. [Google Scholar] [CrossRef]
- Reithner, B.; Brunner, K.; Schuhmacher, R.; Peissl, I.; Seidl, V.; Krska, R.; Zeilinger, S. The G protein α subunit Tga1 of Trichoderma atroviride is involved in chitinase formation and differential production of antifungal metabolites. Fungal Genet. Biol. 2005, 42, 749–760. [Google Scholar] [CrossRef] [PubMed]
- Vinale, F.; Sivasithamparam, K. Beneficial effects of Trichoderma secondary metabolites on crops. Phytother. Res. 2020, 34, 2835–2842. [Google Scholar] [CrossRef]
- Kumar, S.; Thakur, M.; Rani, A. Trichoderma: Mass production, formulation, quality control, delivery and its scope in commercialization in India for the management of plant diseases. Afr. J. Agric. Res. 2014, 9, 3838–3852. [Google Scholar] [CrossRef]
- Chaube, H.S.; Mishra, D.S.; Varshney, S.; Singh, U.S. Biological control of plant pathogens by fungal antagonistc: Historical background, present status and future prospects. Annu. Rev. Plant Pathol. 2003, 2, 1–42. [Google Scholar]
- Khan, R.A.A.; Najeeb, S.; Hussain, S.; Xie, B.; Li, Y. Bioactive secondary metabolites from Trichoderma spp. against phytopathogenic fungi. Microorganisms 2020, 8, 817. [Google Scholar] [CrossRef]
- Awla, H.K.; Kadira, J.; Tavaga, R.C.; Rashidad, S.; Wangae, M. Plant growth-promoting abilities and biocontrol efficacy of Streptomyces sp. UPMRS4 against Pyricularia Oryzae. Biol. Control 2017, 112, 55–63. [Google Scholar] [CrossRef]
- Bora, L.C.; Bora, P.; Gogoi, M. Potential of Trichoderma spp. for pest management and plant growth promotion in NE India. In Trichoderma: Host Pathogen Interactions and Applications; Sharma, A.K., Sharma, P., Eds.; Springer: Singapore, 2020; pp. 205–220. [Google Scholar] [CrossRef]
- Contreras-Cornejo, H.A.; Macías-Rodríguez, L.; del-Val, E.; Larsen, J. Ecological functions of Trichoderma spp. and their secondary metabolites in the rhizosphere: Interactions with plants. FEMS Microbiol. Ecol. 2016, 92, fiw036. [Google Scholar] [CrossRef] [PubMed]
- Hewedy, O.A.; Mansour, A.; Ali, M.G.; Lateif, K.S.A.; Ismaiel, M.H.; El-Meihy, R.M. Comprehensive characterization and screening of different Trichoderma isolates as plant growth promoters: Insight to metal solubilization, enzymatic activity, and antagonistic effect. Rev. Res. Sq. 2022. preprint. [Google Scholar] [CrossRef]
- Kays, S.J.; Nottingham, S.F. Introduction: An underutilized resource. In Biology and Chemistry of Jerusalem artichoke (Helianthus tubrosus L.); Kays, S.J., Nottingham, S.F., Eds.; CRC Press: Boca Raton, FL, USA, 2008; pp. 1–5. [Google Scholar]
- Beltran, J.C.; Stange, C. Apocarotenoids: A new carotenoid-derived pathway. Subcell. Biochem. 2016, 79, 239–272. [Google Scholar] [CrossRef] [PubMed]
- Singh, P.K.; Wasnik, A.B.; Kainthola, A.; Sazid, M.; Singh, T.N. The stability of road cut cliff face along SH-121: A case Study. Nat. Hazards 2013, 68, 497–507. [Google Scholar] [CrossRef]
- Farouk, S.; Belal, B.E.A.; El-Sharkawy, H.H.A. The role of some elicitors on the management of Roumy Ahmar grapevines downy mildew disease and it’s related to inducing growth and yield characters. Sci. Hortic. 2017, 225, 646–658. [Google Scholar] [CrossRef]
- Thakker, J.N.; Patel, S.; Dhandhukia, P.C. Induction of defense-related enzymes in banana plants: Effect of live and dead pathogenic strains of Fusarium oxysporum f. sp. cubense. ISRN Biotechnol. 2013, 2013, 601303. [Google Scholar] [CrossRef]
- Rahman, M.; Punja, Z.K. Biochemistry of ginseng root tissues affected by rusty root symptoms. Plant Physiol. Biochem. 2005, 43, 1103–1114. [Google Scholar] [CrossRef]
- Surekha, C.H.; Neelapu, N.; Prasad, B.S.; Ganesh, P.S. Induction of defense enzymes and phenolic content by Trichoderma viride in Vigna mungo infested with Fusarium oxysporum and Alternaria alternata. Int. J. Agric. Sci. Res. 2014, 4, 31–40. [Google Scholar]
- Singh, J.; Singh, P.; Vaishnav, A.; Ray, S.; Rajput, R.S.; Singh, S.M.; Singh, H.B. Belowground fungal volatiles perception in okra (Abelmoschus esculentus) facilitates plant growth under biotic stress. Microbiol. Res. 2021, 246, 126721. [Google Scholar] [CrossRef]
- Kumar, S.; Chandra, R.; Behera, L.; Keswani, C.; Sansinenea, E. Elevation of systemic defense in potato against Alternaria solani by a consortium of compatible Trichoderma spp. Res. Sq. 2021, 1, 1–20. [Google Scholar] [CrossRef]
- Dildey, O.D.F.; Broetto, L.; Rissato, B.B.; Gonçalves-Trevisoli, E.D.V.; Coltro-Roncato, S.; Dal’Maso, E.G.; Meinerz, C.C.; Henkemeier, N.P.; Stangarlin, J.; José Kuhn, O. Trichoderma-bean interaction: Defense enzymes activity and endophytism. Afr. J. Agric. Res. 2016, 11, 4286–4292. [Google Scholar] [CrossRef]
- Nawrocka, J.; Małolepsza, U.; Szymczak, K.; Szczech, M. Involvement of metabolic components, volatile compounds, PR proteins, and mechanical strengthening in multilayer protection of cucumber plants against Rhizoctonia solani activated by Trichoderma atroviride TRS25. Protoplasma 2018, 255, 359–373. [Google Scholar] [CrossRef]
- Behiry, S.; Soliman, S.A.; Massoud, M.A.; Abdelbary, M.; Kordy, A.M.; Abdelkhalek, A.; Heflish, A. Trichoderma pubescens elicit induced systemic resistance in tomato challenged by Rhizoctonia solani. J. Fungi 2023, 9, 167. [Google Scholar] [CrossRef] [PubMed]

| ID | Retention Time (min) | m/z | Area | Height | Peak Area, % | The Compounds in the Order of Their Elution |
|---|---|---|---|---|---|---|
| 1 | 4.147 | 18 | 5,306,194 | 300,206 | 37.30 | Benzenemethanol, 4-[(1-ethylpropyl)amino]-2-methyl-3,5-dinitr |
| 2 | 40.251 | 74 | 112,485 | 18,189 | 0.79 | Hexadecanoic acid, methyl ester |
| 3 | 40.855 | 55 | 96,629 | 12,072 | 0.68 | 9-Hexadecenoic acid |
| 4 | 41.384 | 43 | 1,509,041 | 228,594 | 10.61 | Octadecanoic acid |
| 5 | - | 57 | - | - | - | Isopropyl linoleate |
| 6 | 44.537 | 55 | 153,693 | 40,184 | 1.08 | 9-Octadecenoic acid (Z)-, methyl ester |
| 7 | 45.663 | 55 | 3,073,127 | 373,559 | 21.60 | cis-Vaccenic acid |
| 8 | 45.728 | 55 | 716,596 | 199,111 | 5.04 | Oleic acid |
| 9 | 45.942 | 67 | 5011 | 1899 | 0.04 | Oxirane, (7-octenyl)- |
| 10 | 46.056 | 43 | 464,698 | 111,056 | 3.27 | Octadecanoic acid |
| 11 | 47.915 | 43 | 259,321 | 79,493 | 1.82 | Palmitic acid vinyl ester |
| 12 | 48.359 | 55 | 78,620 | 11,361 | 0.55 | Oleyl Alcohol |
| 13 | 48.981 | 55 | 214,637 | 62,761 | 1.51 | 13-Docosenoic acid, methyl ester, (Z)- |
| 14 | 51.799 | 55 | 600,665 | 133,963 | 4.22 | Oleoyl chloride |
| 15 | 51.919 | 55 | 125,964 | 21,230 | 0.89 | Oleic anhydride |
| 16 | 52.362 | 43 | 173,558 | 36,751 | 1.22 | Eicosanoic acid, 2-(acetyloxy)-1-[(acetyloxy)methyl]ethyl ester |
| 17 | 53.016 | 55 | 59,189 | 11,389 | 0.42 | 1,2-15,16-Diepoxyhexadecane |
| 18 | 53.318 | 43 | 380,024 | 46,428 | 2.67 | Hexadecanoic acid, 2-hydroxy-1-(hydroxymethyl)ethyl ester |
| 19 | 53.659 | 55 | 29,604 | 7329 | 0.21 | Cyclopropaneoctanoic acid, 2-hexyl-, methyl ester |
| 20 | 59.477 | 55 | 866,355 | 61,073 | 6.09 | Oleyl alcohol, trifluoroacetate |
| Storage (Month) | aw | GBTF Viability (cfu × 105) | |
|---|---|---|---|
| 4 °C | 25 °C | ||
| 0 | 6.10 ± 0.10 a | 6.10 ± 0.10 a | |
| 1 | Control | 5.40 ± 0.10 cd | 4.13 ± 0.15 cd |
| 2 | 4.20 ± 0.11 fgh | 3.20 ± 0.20 e | |
| 3 | 3.53 ± 0.38 I | 2.40 ± 0.36 f | |
| 4 | 2.50 ± 0.10 k | 1.70 ± 0.26 gh | |
| 5 | 2.17 ± 0.15 k | 0.00 ± 0.0 j | |
| 6 | 1.70 ± 0.12 l | 0.00 ± 0.0 j | |
| 1 | 0.125 | 5.58 ± 0.13 bc | 4.62 ± 0.08 bc |
| 2 | 4.58 ± 0.11 ef | 3.73 ± 0.08 de | |
| 3 | 4.37 ± 0.08 efg | 2.37 ± 0.16 f | |
| 4 | 4.17 ± 0.06 gh | 2.05 ± 0.22 fg | |
| 5 | 3.83 ± 0.13 hi | 1.09 ± 0.13 i | |
| 6 | 3.10 ± 0.10 j | 0.53 ± 0.25 j | |
| 1 | 0.570 | 5.88 ± 0.03 ab | 5.69 ± 0.09 a |
| 2 | 5.79 ± 0.04 abc | 5.04 ± 0.19 b | |
| 3 | 5.49 ± 0.06 bc | 4.45 ± 0.11 c | |
| 4 | 5.06 ± 0.08 d | 3.67 ± 0.09 de | |
| 5 | 4.65 ± 0.10 e | 2.38 ± 0.24 f | |
| 6 | 4.02 ± 0.08 gh | 1.30 ± 0.17 hi | |
| Treatment | Total Phenol (mg Catechol 100 g−1 F.W.) | Peroxidase (Uni. min. g−1) | Polyphenol Oxidase (Uni. min. g−1) | Phenylalanine Ammonia-lyase (Uni. h−1 g−1) | Photosynthetic Pigments (mg g−1 F.W.) | ||||
|---|---|---|---|---|---|---|---|---|---|
| Cha. | Chb. | Chls. | Carotenoids | ||||||
| Infected | P | 21.19 ± 0.22 de | 0.00 ± 0.00 b | 0.00 ± 0.00 c | 62.30 ± 8.73 e | 1.340 ± 0.15 b | 0.602 ± 0.17 b | 1.943 ± 0.25 b | 0.166 ± 0.08 abc |
| PGBTF | 31.62 ± 1.27 b | 4.20 ± 0.10 b | 2.31 ± 0.81 bc | 163.00 ± 7.94 a | 2.525 ± 0.37 a | 1.123 ± 0.20 a | 3.648 ± 0.56 a | 0.269 ± 0.01 a | |
| PF | 26.44 ± 0.23 c | 4.24 ± 0.58 b | 0.00 ± 0.00 c | 77.70 ± 11.50 cd | 2.354 ± 0.68 a | 1.095 ± 0.27 a | 3.448 ± 0.55 a | 0.258 ± 0.05 ab | |
| Noninfected | NC | 20.64 ± 0.51 e | 0.00 ± 0.00 b | 0.00 ± 0.00 c | 99.00 ± 5.29 cd | 1.935 ± 0.01 ab | 1.043 ± 0.01 a | 2.978 ± 0.02 ab | 0.161 ± 0.01 bc |
| GBTF | 37.68 ± 1.40 a | 62.27 ± 5.54 a | 66.53 ± 0.00 a | 124.00 ± 5.29 b | 2.477 ± 0.11 a | 1.304 ± 0.06 a | 3.781 ± 0.16 a | 0.138 ± 0.02 c | |
| F | 24.35 ± 2.26 cd | 11.49 ± 1.46 b | 4.17 ± 1.83 b | 101.00 ± 3.79 bc | 2.252 ± 0.19 a | 1.025 ± 0.09 a | 3.277 ± 0.29 a | 0.221 ± 0.02 abc | |
Disclaimer/Publisher’s Note: The statements, opinions and data contained in all publications are solely those of the individual author(s) and contributor(s) and not of MDPI and/or the editor(s). MDPI and/or the editor(s) disclaim responsibility for any injury to people or property resulting from any ideas, methods, instructions or products referred to in the content. |
© 2023 by the authors. Licensee MDPI, Basel, Switzerland. This article is an open access article distributed under the terms and conditions of the Creative Commons Attribution (CC BY) license (https://creativecommons.org/licenses/by/4.0/).
Share and Cite
Ghoneem, K.M.; Al-Askar, A.A.; Saber, W.I.A. A Simple Formula of the Endophytic Trichoderma viride, a Case Study for the Management of Rhizoctonia solani on the Common Bean. Life 2023, 13, 1358. https://doi.org/10.3390/life13061358
Ghoneem KM, Al-Askar AA, Saber WIA. A Simple Formula of the Endophytic Trichoderma viride, a Case Study for the Management of Rhizoctonia solani on the Common Bean. Life. 2023; 13(6):1358. https://doi.org/10.3390/life13061358
Chicago/Turabian StyleGhoneem, Khalid M., Abdulaziz A. Al-Askar, and WesamEldin I. A. Saber. 2023. "A Simple Formula of the Endophytic Trichoderma viride, a Case Study for the Management of Rhizoctonia solani on the Common Bean" Life 13, no. 6: 1358. https://doi.org/10.3390/life13061358
APA StyleGhoneem, K. M., Al-Askar, A. A., & Saber, W. I. A. (2023). A Simple Formula of the Endophytic Trichoderma viride, a Case Study for the Management of Rhizoctonia solani on the Common Bean. Life, 13(6), 1358. https://doi.org/10.3390/life13061358

